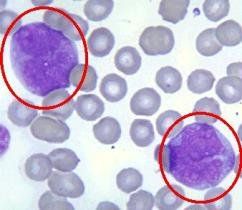
單核細胞 單核細胞

生理學變異
⒈升高 吸菸約高22%,月經周期的卵泡期偏高,周與周變異約高19%,小時與小時變異約高18%,天與天的變異約高13%。
⒉降低 妊娠約低4%,高海拔約低27%。
病理學變異
⒈增加 見於骨髓單核細胞綜合徵、單核細胞增多症。
單核細胞增多症可發生於惡性新生物、貧血、瘧疾和黑熱病及原蟲感染各種疾病中,也可發生梅毒、進行性結核、病毒性肝炎、敗血症、心內膜炎、甲亢和結節性關節炎等疾病。
⒉減少 見於急、慢性淋巴細胞白血病和全骨髓功能不全。
用途
單核細胞單核細胞能吞噬異物產生抗體,在機體損傷治癒、抗禦病原的入侵和對疾病的免疫方面起著重要的作用。
機體發生炎症或其他疾病都可引起單核細胞總數百分比發生變化,因此檢查單核細胞計數成為輔助診斷的一種重要方法。在機體的防護、免疫和創傷愈治過程中起協同作用。儘管它們是血液中的一類細胞成分,但它們功能的發揮,更多地體現在循環管道外的器官組織中。在功能方面它們與這些器官組織中的許多細胞成分如巨噬細胞、肥大細胞、成纖維細胞等密切相關。
特異性免疫功能淋巴細胞也稱免疫細胞,在機體特異性免疫過程中起主要作用。所謂特異性免疫,就是淋巴細胞針對某一種特異性抗原,產生與之相對應的抗體或進行局部性細胞反應,以殺滅特異性抗原。血液中淋巴細胞按其發生和功能的差異,分為T淋巴細胞和B淋巴細胞兩類。
(1)細胞免疫細胞免疫主要是由T細胞來實現的。這種細胞在血液中占淋巴細胞總數的80%~90%。T細胞受抗原刺激變成致敏細胞後,其免疫作用表現以下三個方面。直接接觸並攻擊具有特異抗原性的異物,如腫瘤細胞,異體移植細胞;分泌多種淋巴因子,破壞含有病原體的細胞或抑制病毒繁殖;B細胞與T細胞起協同作用,互相加強,來殺滅病原微生物。
(2)體液免疫體疫免疫主要是通過B細胞來實現的。當此細胞受到抗原刺激變成具有免疫活性的漿細胞後,產生並分泌多種抗體,即免疫球蛋白,以針對不同的抗原。B細胞內有豐富的粗面內質網,蛋白質合成旺盛。抗體通過與相應抗原發生免疫反應,抗體能中和、沉澱、凝集或溶解抗原,以消除其對抗體的有害作用。
嗜鹼性和嗜酸性粒細胞的功能這兩種細胞在血液中停留時間不長,主要在組織中發生作用。
(1)嗜鹼性粒細胞這類細胞的顆粒內含有組織胺、肝素和過敏性慢反應物質等。肝素有抗凝血作用,組織胺可改變毛細血管的通透性。過敏性慢反應物質是一種脂類分子,能引起平滑肌收縮。機體發生過敏反應與這些物質有關。嗜鹼性細胞在結締組織和黏膜上皮內時,稱肥大細胞,其結構和功能與嗜鹼性細胞相似。
(2)嗜酸性粒細胞這類細胞平時只占白細胞總數的3%,但在患有過敏反應及寄生蟲病時其數量明顯增加,如感染裂體吸蟲病時,嗜酸性粒細胞可達90%。這類細胞吞噬細菌能力較弱,但吞噬抗原-抗體複合物的能力較強。此外,這類細胞尚能限制嗜鹼性粒細胞和肥大細胞在過敏反應中的作用。
結構特點
單核細胞單核細胞是機體防禦系統的一個重要組成部分。它通過吞噬和產生抗體等方式來抵禦和消滅入侵的病原微
生物。
吞噬作用是生物體最古老的,也是最基本的防衛機制之一。對於其要消滅的對象無特異性,在免疫學中稱之為非特異性免疫作用。中性粒細胞和單核細胞的吞噬作用很強,嗜酸性粒細胞雖然遊走性很強,但吞噬能力較弱。
單核細胞可以通過毛細血管的內皮間隙,從血管內滲出,在組織間隙中遊走。它們吞噬侵入的細菌、病毒、寄生蟲等病原體和一些壞死的組織碎片。一般認為,單核細胞能向異物處聚集,並將其吞噬,這是因為單核細胞有趨化性。由於細菌體或死亡的細胞所產生的化學刺激,誘發單核細胞向該處移動。組織發炎時產生一種活性多肽,也是單核細胞遊動的誘發物質之一。
中性粒細胞內的顆粒為溶酶體,內含多種水解酶,能消化其所攝取的病原體或其他異物。一般一個白細胞處理5~25個細菌後,本身也就死亡。死亡的白細胞集團和細菌分解產物構成膿液。單核細胞由骨髓生成,在血液內僅生活3~4天,即進入肝、脾、肺和淋巴等組織轉變為巨噬細胞。變為巨噬細胞後,體積加大,溶酶體增多,吞噬和消化能力也增強。但其吞噬對象主要為進入細胞內的致病物,如病毒、瘧原蟲和細菌等。巨噬細胞還參與激活淋巴細胞的特異免疫功能。此外,它還具有識別和殺傷腫瘤細胞,清除衰老與損傷細胞的作用。
單核細胞:約占3%,體積大,胞質豐富,染成灰藍色,胞核常呈腎形或馬蹄形,細胞形狀不一,有圓形,多角形。自動計數儀法為男性0.003-1.3×109/L,女性0.002-1.1×109/L
臨床病例
單核細胞傳染性單核細胞增多症(infectiousmononucleosis)是一種急性的單核-巨噬細胞系統增生性疾病病程常具
自限性。臨床上表現為不規則發熱、淋巴結腫大咽痛、周圍血液單核細胞顯著增多,並出現異常淋巴細胞嗜異性凝集試驗陽性,血清中可測得抗EB病毒的抗體等。在青年與成年發生的EB病毒原發性感染者約有半數表現為傳染性單核細胞增多症。非洲兒童的Burkittis淋巴瘤(BL和鼻咽癌僅發生在曾感染過EB病毒的患者,且在BL和鼻咽癌的腫瘤細胞中均帶有EB病毒的DNA以及病毒決定的核抗原故認為EB病毒可能是BL和鼻咽癌的重要致病因素。
急性粒、單核細胞白血病(簡稱急粒單,ANUL-M5)。骨髓或(和)外周血中有粒和單核兩系細胞,或是"急粒單"的原始細胞既具粒系、又具單核系形態特徵。如以原粒和早幼粒細胞增生為主,則原幼單和單核細胞應超過20%;如以原幼單核細胞增生為主,則原粒和早幼粒細胞應超過20%。
在臨床上,"急粒單"(和"急?quot;一樣)的表現有以下特點:
(1)齒齦增生、腫脹、出血、潰瘍、壞死等較多見;
(2)鼻黏膜浸潤、鼻塞、嗅覺減退、硬齶潰爛、咽喉水腫引起窒息等;
(3)皮膚白血病病損多見,可表現為彌散性斑丘疹,硬性結節,腫塊,膿皰性、大皰性或剝脫性皮炎等;
(4)腸壁浸潤、潰瘍、胃腸功能紊亂等相對易見;
(5)腎功能衰竭、蛋白尿較多見,與單核細胞及粒細胞富含溶菌酶-易形成溶菌酶血症及溶菌酶尿有關;
(6)關節疼痛與腫脹相對多見;
(7)在治療上,急粒單與急單的療效較其他急性非淋巴細胞白血病為差。
異常狀態
生理學變異
單核細胞⒈升高 吸菸約高22%,月經周期的卵泡期偏高,周與周變異約高19%,小時與小時變異約吭18%,天
與天的變異約高13%。
⒉降低 妊娠約低4%,高海拔約低27%。
藥物影響
灰黃黴素引起粒細胞暫時減少,單核細胞相對增加。氨苄青黴素引起單核細胞增加伴粒細胞缺乏。氯丙嗪致在粒細胞缺乏前偶見單核細胞增加。
病理學變異
⒈增加 見於骨髓單核細胞綜合徵、傳染性單核細胞增多症和單核細胞增多症。
單核細胞增多症可發生於惡性新生物、貧血、瘧疾和黑熱病及原蟲感染各種疾病中,也可發生梅毒、進行性結核、病毒性肝炎、敗血症、心內膜炎、甲亢和結節性關節炎等疾病。
⒉減少 見於急、慢性淋巴細胞白血病和全骨髓功能不全。
主題詞或關鍵字: 單核細胞 生化指標 血液檢查
相關疾病: 心內膜炎 白血病 肺結核
相關指標: 單核細胞直接計數 抗人球蛋白試驗 淋巴細胞 白細胞計數 血清結合珠蛋白定量測定